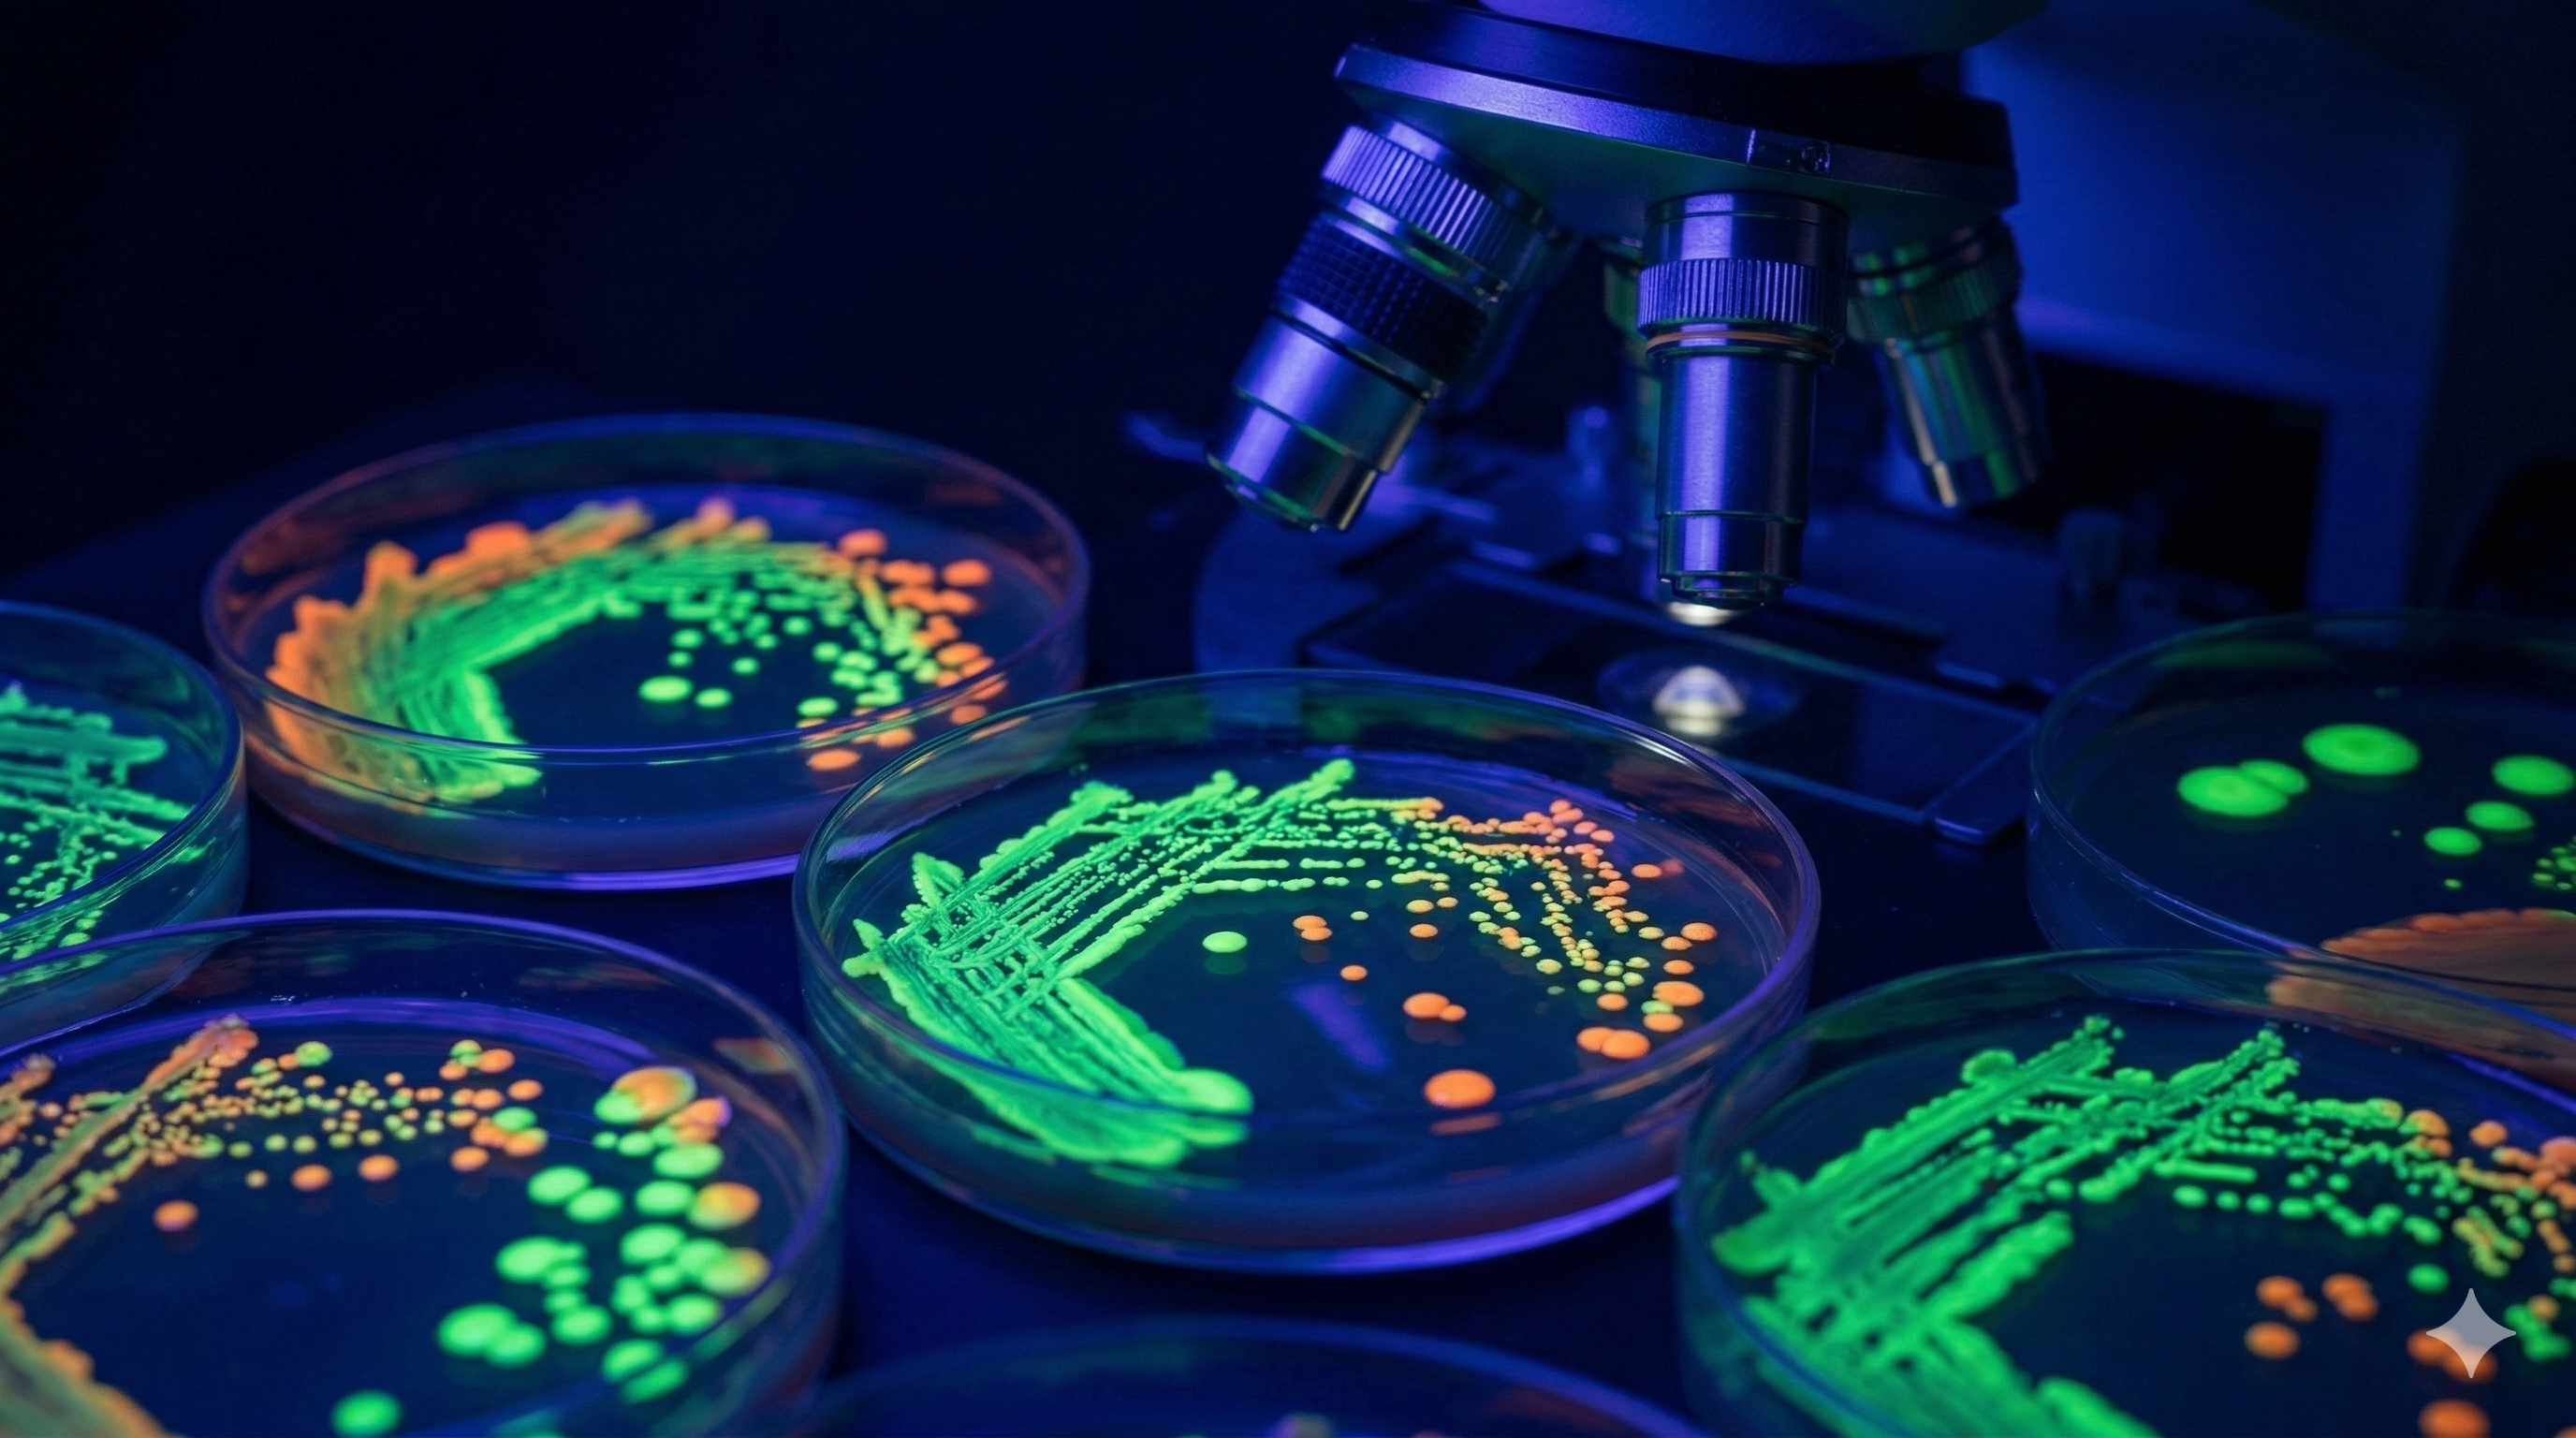
Microbiological Testing

Empowering
Environmental Excellence
Leading the convergence of Science, Nature & Technology — delivering precision environmental testing and sustainable consultancy solutions.
100+
Clients
500+
Projects
9+
Services
Our Core Domains
Specialized environmental testing and consultancy services across multiple domains
Clients Served
Projects Completed
Team Members
Years Experience
Our Services
Comprehensive environmental testing and consultancy services with NABL-accredited precision
Why Choose ECOBIOCARE
Trusted by 100+ organizations across Odisha for environmental testing and consultancy
NABL Accredited
Our laboratory is NABL-accredited, ensuring internationally recognized testing standards and reliable results.
Fast Turnaround
Quick sample processing with reliable results delivered within agreed timelines.
Regulatory Compliance
Complete compliance with CPCB, SPCB, and other regulatory requirements for environmental monitoring.
Precision Testing
State-of-the-art instruments including AAS, ICP-OES, and high-precision analyzers.
End-to-End Solutions
From sample collection to regulatory filing, we provide complete environmental consultancy.
Expert Team
Qualified environmental scientists, engineers, and lab technicians with years of experience.
Our Lab & Field Work
A glimpse into our NABL-accredited laboratory and on-site environmental monitoring activities across Odisha

Advanced analytical instruments in our NABL lab

Scientists conducting chemical analysis

Microscopy and digital analysis workstation

Microscope with reagents for microbiological testing

Modern laboratory facility with distillation setup

Researchers performing water quality analysis

Field research team conducting soil analysis

Environmental monitoring equipment setup

Biodiversity assessment in natural habitat

Water quality testing in field conditions

Ecological survey and data collection

Wildlife observation and documentation

Plant species identification and cataloging

Remote sensing and geospatial mapping

Community engagement in conservation efforts

Climate data recording in field station

Forest ecosystem health assessment

Sustainable land management demonstration
Our Esteemed Clients
Trusted by leading industries, institutions, and organizations across Odisha
Ready to Get Your Samples Tested?
Contact us today for a free consultation. Our team of experts is ready to help you with environmental testing, compliance, and consultancy needs.